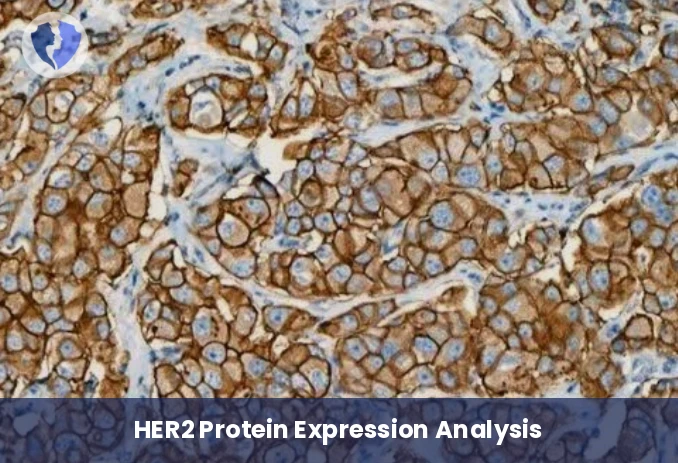
HER2 Breast & Gastric Cancer Test - HER2 Immunohistochemistry Test

Service Details
HER2 Breast & Gastric Cancer Test - HER2 Immunohistochemistry Test
Immunohistochemical (IHC) testing for human epidermal growth factor receptor 2 (HER2/neu) aims to detect overexpression of HER2 on the cell membrane of breast and gastric cancers. This test is a crucial first step (followed by in situ hybridization - ISH in borderline cases) in determining patient eligibility for anti-HER2 antibody therapy, a global standard in the management of breast and gastric cancers.